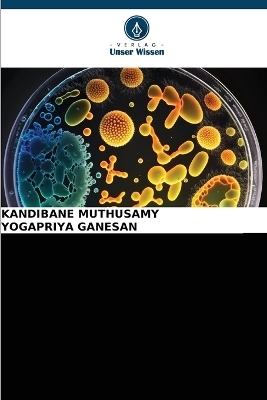
AKTUELLE FORTSCHRITTE bei Bacillus thuringiensis - Kandibane Muthusamy, YOGAPRIYA GANESAN

AKTUELLE FORTSCHRITTE bei Bacillus thuringiensis
Seiten
2025
Verlag Unser Wissen
978-620-2-19534-8 (ISBN)
Verlag Unser Wissen
978-620-2-19534-8 (ISBN)
- Titel nicht im Sortiment
- Artikel merken
Bacillus thuringiensis (B.t.) ist ein gram-positives Bodenbakterium, das als eines der Entomopathogene zur Bekämpfung von Lepidoptera-Schädlingen auf Feldern und in Gartenbaukulturen eingesetzt wird. Die verschiedenen Formulierungen von B.t. wurden erfolgreich eingesetzt, um die Umwelt und Lebensmittel vor der Kontamination durch chemische Pestizidrückstände in der Schädlingsbekämpfung zu schützen. Die Entdeckung von B.t. -Toxinen mit neuartiger insektizider Wirkung gegen Schädlinge und die Entwicklung gentechnisch veränderter Pflanzen eröffnete eine neue Ära der Schädlingsbekämpfung. Transgene B.t. -Pflanzen, darunter Mais, Baumwolle und Sojabohnen, wurden inzwischen produziert und vermarktet, um Nutzpflanzen vor etwa 30 wichtigen Coleoptera- und Lepidoptera-Schädlingen zu schützen, was der Umwelt und der Wirtschaft sehr zugute kommt. Mit dem langfristigen Anbau von B.t. -Pflanzen haben einige der Zielschädlinge jedoch allmählich eine Resistenz entwickelt. Zahlreiche Studien haben gezeigt, dass Mutationen in Genen für die Aktivierung von Toxinen, die Bindung von Toxinen und die Immunisierung von Insekten wichtige Ursachen für die B.t.-Resistenz sind. Eine eingehende Untersuchung der entsprechenden Resistenzmechanismen von B.t. wird bei der Entwicklung neuer Strategien zur Vorbeugung und Bekämpfung von Schädlingen helfen.
Der Autor arbeitet seit 2006 als Professor (Agrarentomologie) bei PAJANCOA & RI, Karaikal, Unionsterritorium Puducherry, Indien. Der Autor verfügt über neunzehn Jahre Erfahrung in der Lehre, Forschung und Beratung. Innerhalb von zehn Jahren hat er 23 postgraduierte Entomologiestudenten betreut.
| Erscheinungsdatum | 16.09.2025 |
|---|---|
| Sprache | deutsch |
| Maße | 152 x 229 mm |
| Gewicht | 145 g |
| Themenwelt | Naturwissenschaften ► Biologie ► Botanik |
| Weitere Fachgebiete ► Land- / Forstwirtschaft / Fischerei | |
| Schlagworte | Bacillus • Bakterien • Management • Schädlinge |
| ISBN-10 | 620-2-19534-7 / 6202195347 |
| ISBN-13 | 978-620-2-19534-8 / 9786202195348 |
| Zustand | Neuware |
| Informationen gemäß Produktsicherheitsverordnung (GPSR) | |
| Haben Sie eine Frage zum Produkt? |
Mehr entdecken
aus dem Bereich
aus dem Bereich
Gefäßpflanzen: Grundband
Buch | Hardcover (2021)
Springer Spektrum (Verlag)
CHF 62,95
ein Baum erzählt seine erstaunliche Geschichte
Buch | Hardcover (2024)
Ludwig (Verlag)
CHF 32,15


